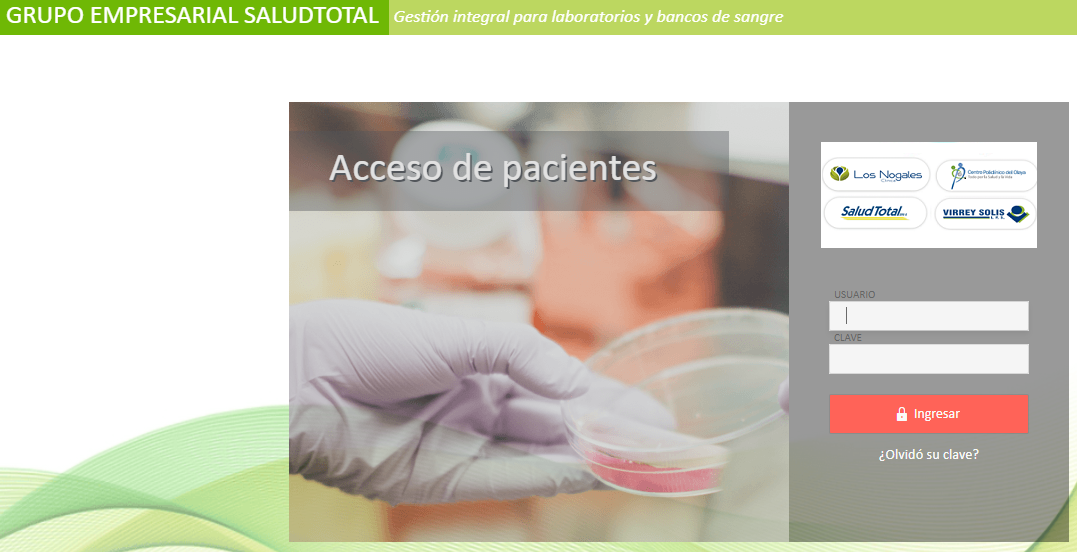

Ingresa a la URL: https://laboratorio.cpo.com.co:82/paciente
En lo botones «Ingresa Aquí» ó escanee el código QR.
Ingresa a la URL: https://laboratorio.cpo.com.co:82/paciente
En lo botones «Ingresa Aquí» ó escanee el código QR.

Ingresa con tu usuario y contraseña
Usuario: Ingresa tu tipo de documento de identidad, seguido del Número de Documento.
Ej: CC1050000001
Contraseña: Tu fecha de nacimiento, formato díaMesAño.
Ejemplo: 13121981
Actualiza tus datos de contacto.

Ir a Reportes/ Ordenes del paciente
Seleeciona el rango de fechas en que te realizaste el examen. Con estado PUBLICADA. Así se podrá descargar haciendo clic en la impresora.
No lo olvides cierra la sesión al finalizar.